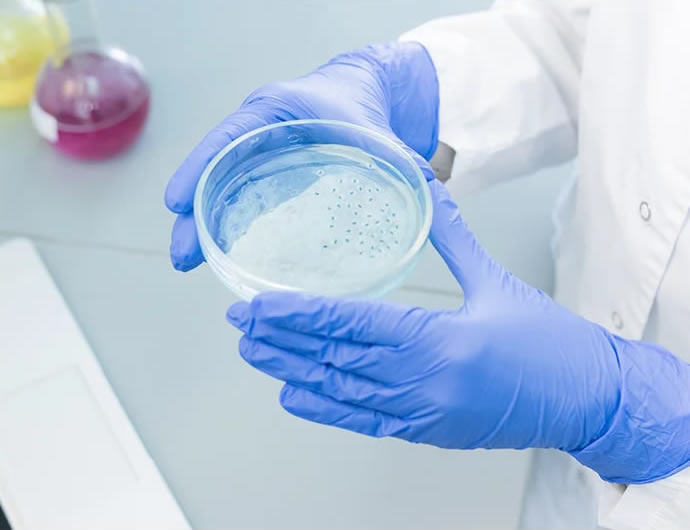

Contacto
-
contacto@bioquid.com.mx

BIOQUID

BIOQUID

BIOQUID

BIOQUID

BIOQUID

BIOQUID

BIOQUID
BIOQUID

BIOQUID